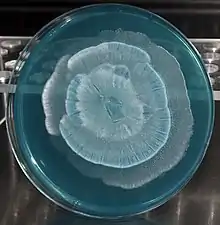

| Mortierella | |
|---|---|
![]() | |
| Scientific classification | |
| Kingdom: | |
| Phylum: | |
| Order: | |
| Family: | |
| Genus: | Mortierella Coem. (1863) |
| Type species | |
| Mortierella polycephala Coem. (1863) | |
| Species | |
| Synonyms[1] | |
|
Actinomortierella Chalab. (1968) | |
Mortierella species are soil fungi belonging to the order Mortierellales within the subphylum Mortierellomycotina (phylum: Mucoromycota).[2] The widespread genus contains about 85 species.[3]
Taxonomy
The genus name of Mortierella is in honour of the Belgian Barthélemy Dumortier (1797–1878), a botanist and Member of Parliament.[4]
The genus was circumscribed by Henri Eugène Lucien Gaëtan Coemans in Bull. Acad. Roy. Sci. Belgique series 2, Vol.15 on pages 536–539 in 1863.
Ecology
Species of Mortierella live as saprotrophs in soil, on decaying leaves and other organic material. Other species live on fecal pellets or on exoskeletons of arthropods.[5][6] Penicillium, Trichoderma, Mucor and Mortierella species belong to an ecology group which are the first organisms growing on roots. Salt described that the frequency of Mortierella species growing on the surface of roots from spruce is higher in comparison to other species (e.g. Fusarium, Pythium etc.).[7]
(Distribution map on EOL)
Morphology
Mortierella fungi are typically coenocytic, but compared with the genus Mucor (Mucoromycotina, Mucorales), they have a stronger tendency towards septum formation. Compared with Mucor-like fungi, the mitosporangia are typically smaller, contain fewer spores and lack a columella (Fig. 1). Many Mortierella-like fungi are asexual. However, if zygospores are found, they strongly resemble Mucor-zygospores. Sometimes sexual structures are embedded in loosely arranged hyphal networks.
Metabolism
Mortierella can grow on yeast extract, fish meal, or other media rich in nutrients. Most laboratories grow these fungi on potato dextrose agar or corn meal agar. The genus can also grow on PARP media, which is used as a common selective medium for Pythium. Because of its similar appearance to Pythium in culture, separation of the two can be difficult until sporulation occurs. Cultivation and growth of Mortierella fungi are affected by the carbon source, addition of minerals and nitrogen source. Monosaccharides are most frequently used for the growth.[8] Yeast extract and soybean meal are widely used as nitrogen source.[9][10] Especially the balance between carbon and nitrogen in the medium influences the fungal culture.
Many Mortierella spp. are chitinolytic. Experiments show that they degrade chitin nearly as efficiently as chitinolytic actinomycetes. From some Mortierella species it is also known that they are able to degrade hemicelluloses to sugar by using the enzyme xylanase. This fungus can degrade the hemicellulose from plants to get sugars for their growth.[11]
Sexual and asexual development





Some Mortierella species show sexual developmental programs in addition to mitotic reproduction.
Mortierella forms zygospores that are the developmental consequence of plasmogamy between gametangia belonging to complementary mating types. The zygospores of Mortierella spp. may be naked (Fig 2 A) or surrounded by sterile hyphae (Fig 2 B) that form a nest-like structure, which may be interpreted as evolutionary early fruiting bodies.
Some Mortierella species are homothallic (M. epigama, M. parvispora, M. nigrescens, M. rostafinskii, M. polycephala, M.renispora), but most are heterothallic (M. elongata, M. marburgensis, M. umbelata, M. capitata, M. indohi).[12] The species Mortierella alpina was found to be homothallic and to form zygospores with a hyphal coat. Most Mortierella species have been found to be heterothallic and to produce naked zygospores with unequal suspensors. Very often sexual structures differ in size between mating types. The smaller suspensor, progametangium or gametangium does not enlarge during sexual development and may disappear soon after plasmogamy. The early development of such heterogametangic zygospores is illustrated in the heterothallic species, M. umbellata. In this species, hyphal coiling occurs at the contact site of sexually compatible mycelia. This is followed by development of progametangia which grow in parallel and close to each other. At the end of this development, one partner, the macroprogametangium will be larger than the other, the microprogametangium.
Biotechnology
Umbelopsis isabellina, which used to be mis-classified as Mortierella isabellina, produces γ-linolenic acid, an important poly-unsaturated fatty acid. It was re-classified as belonging to the genus Umbelopsis in part based on its fatty acid profile, in addition to classical ribosomal DNA sequencing. Various poly-unsaturated fatty acids including arachidonic acid are produced by Mortierella alpina. Poly-unsaturated fatty acids contain two or more double bonds and are the acyl components of cellular lipids. Today, long-chain poly-unsaturated fatty acids are regarded as substances with beneficial potential in pharmaceutic and nutritional applications. They also serve a wide variety of purposes, from being a purely structural element in phospholipids to being involved in signal transduction, and as a substrate for a host of derivatives involved in second messenger function.[13] Many species of the genus Mortierella have been found to yield exceptionally high quantities of arachidonic acid depending on the fermentation media and culture conditions.[14] Fatty acids are normally produced in submerged culture with high carbon source supply, although this technique has drawbacks with respect to energy consumption and waste water production. In the long run, fatty acid fermentation needs to be done under economically reasonable solid-state fermentation conditions.
Pathogenicity
Mortierella species are usually non-pathogenic for plants or animals and humans. A rare example for a pathogen is Mortierella wolfii, which is until now the only pathogen of humans and other animals. Mortierella wolfii, normally isolated from soil, rotten silage and similar substrates, causes bovine abortion, pneumonia and systemic mycosis.[15]
References
- ↑ "Mortierella Coem. 1863". MycoBank. International Mycological Association. Retrieved 2011-01-15.
- ↑
- Spatafora, Joseph W.; Chang, Ying; Benny, Gerald L.; Lazarus, Katy; Smith, Matthew E.; Berbee, Mary L.; Bonito, Gregory; Corradi, Nicolas; Grigoriev, Igor; Gryganskyi, Andrii; James, Timothy Y.; O’Donnell, Kerry; Roberson, Robert W.; Taylor, Thomas N.; Uehling, Jessie; Vilgalys, Rytas; White, Merlin M.; Stajich, Jason E. (2016). "A phylum-level phylogenetic classification of zygomycete fungi based on genome-scale data". Mycologia. Informa UK Limited. 108 (5): 1028–1046. doi:10.3852/16-042. ISSN 0027-5514. PMC 6078412. PMID 27738200.
- ↑ Kirk PM, Cannon PF, Minter DW, Stalpers JA (2008). Dictionary of the Fungi (10th ed.). Wallingford, UK: CABI. p. 439. ISBN 978-0-85199-826-8.
- ↑ Burkhardt, Lotte (2022). Eine Enzyklopädie zu eponymischen Pflanzennamen [Encyclopedia of eponymic plant names] (pdf) (in German). Berlin: Botanic Garden and Botanical Museum, Freie Universität Berlin. doi:10.3372/epolist2022. ISBN 978-3-946292-41-8. Retrieved January 27, 2022.
- ↑ Webster, J. and Weber, R. W. S. Introduction to fungi. Cambridge University Press, 2007.
- ↑ Deacon, J.W. Fungal Biology Bd. 4. Blackwell, 2005.
- ↑ Salt, G.A. "The incidence of root-surface fungi on naturally regenerated Picea sitchensis seedlings in Southeast Alaska." Forestry (1977).
- ↑ Chesters, C.G.C.; Peberdy, J.F. (1965). "Nutritional factors in relation to growth and fat synthesis in Mortierella vinacea". J. Gen. Microbiol. 41: 127–134. doi:10.1099/00221287-41-1-127.
- ↑ Aki, T.; Suzuki, O. (2001). "Production of arachidonic acid by filamentous fungus, Mortierella alliacea strain YN-15". J. Am. Oil Chem. Soc. 78: 599–604. doi:10.1007/s11746-001-0311-2.
- ↑ Park, E.Y.; Fujikawa, S. (2001). "Morphological diversity of Mortierella alpina: Effect of consumed carbon to nitrogen ratio in flask culture". Biotechnol. Bioprocess Eng. 6: 161–166. doi:10.1007/bf02932544.
- ↑ Dix N.J. and Webster, J. Fungal Ecology Bd. 1. Chapman and Hall, 1995.
- ↑ Watanabe, T. "Zygospore induction in Mortierella chlamydospora by the soaking-plain-water-agarculture method". Mycologia. 1990: 278–282.
- ↑ Nisha, A. and G. Venkateswaran. "Optimization of media components for enhanced arachidonic acid production by Mortierella alpina under submerged cultivation." Biotechnol. Bioprocess Eng. 16 (2011): 229–237 .
- ↑ Nisha, A.; Venkateswaran, G. (2009). "Safety evaluation of arachidonic acid rich Mortierella alpina biomass in albino rats – a subchronic study". Regul. Toxicol. Pharmacol. 3: 186–194.
- ↑ Davies, J.L.; Wobeser, G.A. (2010). "Systemic infection with Mortierella wolfii following abortion in a cow". Can. Vet. J. 51: 1391–3.